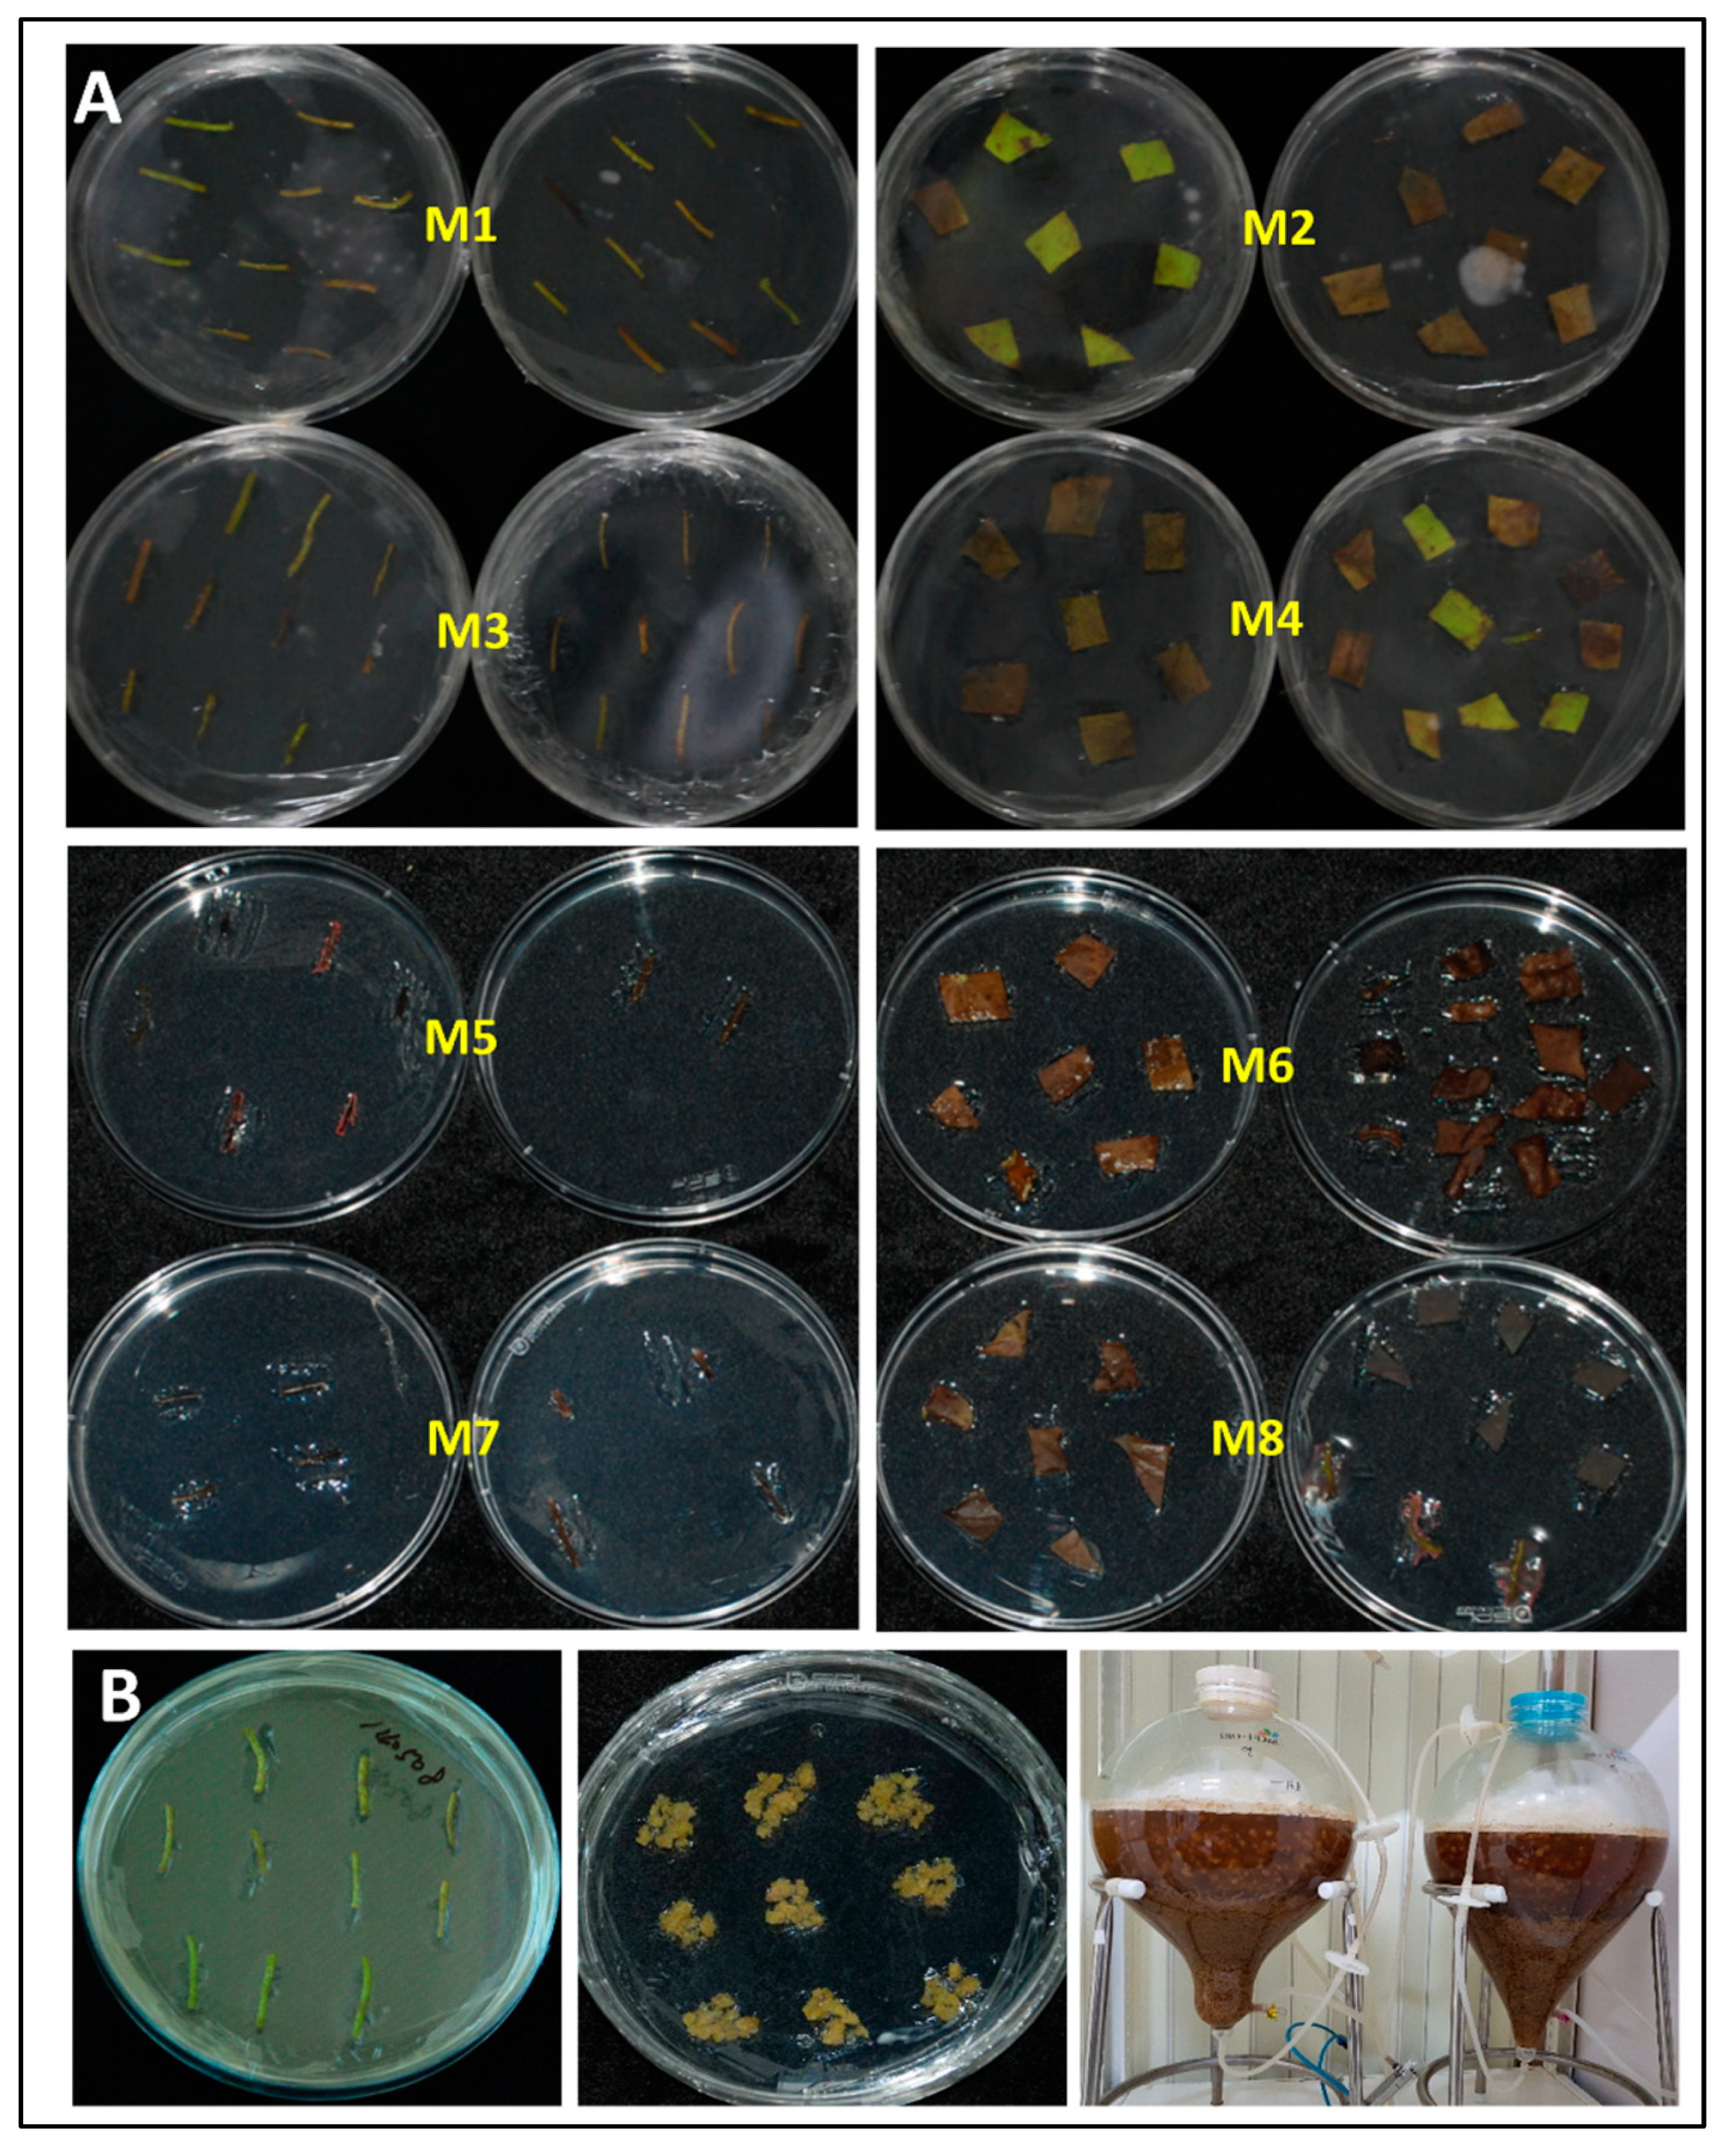
Plants 12 03923 g003

Skin-Whitening Effect of a Callus Extract of Nelumbo nucifera Isolate Haman
Abstract
:1. Introduction
2. Results
2.1. Seed Germination, Callus Induction, Cell Culture, Extraction
2.2. Measurement of Cell Viability
2.3. Measurement of Melanin Content
2.4. Quantitative Real-Time Polymerase Chain Reaction (PCR)
2.5. Clinical Tests
3. Materials and Methods
3.1. Seed Germination, Callus Induction, and Culture
3.2. Callus Suspension Culture
3.3. Extraction of Lotus Callus Isolate HAMAN
3.4. Melanocyte Culture and HLCE Treatment
3.5. Measurement of Cell Viability
3.6. Measurement of Melanin Content
3.7. qRT-PCR
3.8. Cream Formulation
3.9. Clinical Test
3.10. Statistical Analysis
4. Discussion
5. Conclusions
Supplementary Materials
Author Contributions
Funding
Data Availability Statement
Acknowledgments
Conflicts of Interest
References
- Zhang, M.; Feng, S.; Wang, L.; Zheng, Y. Lotus effect in wetting and self-cleaning. Biotribology 2016, 5, 31–43. [Google Scholar]
- Kim, J.-H.; Kang, M.; Cho, C.; Chung, H.-S.; Kang, C.-W.; Parvez, S.; Bae, H. Effects of Nelumbinis Semen on contractile dysfunction in ischemic and reperfused rat heart. Arch. Pharmacal Res. 2006, 29, 777–785. [Google Scholar] [CrossRef]
- Hu, M.; Skibsted, L.H. Antioxidative capacity of rhizome extract and rhizome knot extract of edible lotus (Nelumbo nucifera). Food Chem. 2002, 76, 327–333. [Google Scholar] [CrossRef]
- Cho, E.; Yokozawa, T.; Rhyu, D.; Kim, S.; Shibahara, N.; Park, J. Study on the inhibitory effects of Korean medicinal plants and their main compounds on the 1,1-diphenyl-2-picrylhydrazyl radical. Phytomedicine 2003, 10, 544–551. [Google Scholar]
- Sohn, D.-H.; Kim, Y.-C.; Oh, S.-H.; Park, E.-J.; Li, X.; Lee, B.-H. Hepatoprotective and free radical scavenging effects of Nelumbo nucifera. Phytomedicine 2003, 10, 165–169. [Google Scholar] [CrossRef]
- Mukherjee, P.K.; Saha, K.; Das, J.; Pal, M.; Saha, B.P. Studies on the anti-inflammatory activity of rhizomes of Nelumbo nucifera. Phytomedicine 1997, 63, 367–369. [Google Scholar]
- Onishi, E.; Yamada, K.; Yamada, T.; Kaji, K.; Inoue, H.; Seyama, Y.; Yamashita, S. Comparative effects of crude drugs on serum lipids. Chem. Pharm. Bull. 1984, 32, 646–650. [Google Scholar] [CrossRef]
- Ganesh, V.A.; Raut, H.K.; Nair, A.S.; Ramakrishna, S.J. A review on self-cleaning coatings. J. Mater. Chem. 2011, 21, 16304–16322. [Google Scholar]
- Bhushan, B. Bioinspired structured surfaces. Langmuir 2012, 28, 1698–1714. [Google Scholar] [CrossRef]
- Shen-Miller, J.; Schopf, J.W.; Harbottle, G.; Cao, R.J.; Ouyang, S.; Zhou, K.S.; Southon, J.R.; Liu, G.H. Long-living lotus: Germination and soil gamma-irradiation of centuries-old fruits, and cultivation, growth, and phenotypic abnormalities of offspring. Am. J. Bot. 2002, 89, 236–247. [Google Scholar] [CrossRef]
- Elkhateeb, W.A.; Daba, G.M.; Elnahas, M.O.; Thomas, P.W.; Emam, M. Metabolic profile and skin-related bioactivities of Cerioporus squamosus hydromethanolic extract. J. Biol. Divers. 2020, 21, 4732–4740. [Google Scholar] [CrossRef]
- Sharma, A.; Gupta, S.; Sarethy, I.P.; Dang, S.; Gabrani, R.J. Green tea extract: Possible mechanism and antibacterial activity on skin pathogens. Food Chem. 2012, 135, 672–675. [Google Scholar] [CrossRef]
- Akhtar, N.; Zaman, S.U.; Khan, B.A.; Amir, M.N.; Ebrahimzadeh, M.A. Calendula extract: Effects on mechanical parameters of human skin. Acta Pol. Pharm. 2011, 68, 693–701. [Google Scholar]
- Middelkamp-Hup, M.A.; Pathak, M.A.; Parrado, C.; Goukassian, D.; Rius-Díaz, F.; Mihm, M.C.; Fitzpatrick, T.B.; González, S. Oral Polypodium leucotomos extract decreases ultraviolet-induced damage of human skin. J. Am. Acad. Dermatol. 2004, 51, 910–918. [Google Scholar]
- Ikeuchi, M.; Sugimoto, K.; Iwase, A. Plant callus: Mechanisms of induction and repression. Plant Cell 2013, 25, 3159–3173. [Google Scholar] [CrossRef]
- Fehér, A. Callus, dedifferentiation, totipotency, somatic embryogenesis: What these terms mean in the era of molecular plant biology? Front. Plant Sci. 2019, 10, 536. [Google Scholar] [CrossRef]
- Miyamoto, T.; Tsuchiya, K.; Numata, K. Dual peptide-based gene delivery system for the efficient transfection of plant callus cells. Biomacromolecules 2020, 21, 2735–2744. [Google Scholar] [CrossRef]
- Zafar, R.; Ali, S.M. Anti-hepatotoxic effects of root and root callus extracts of Cichorium intybus L. J. Ethnopharmacol. 1998, 63, 227–231. [Google Scholar] [CrossRef]
- Arumugam, S.; Kavimani, S.; Kadalmani, B.; Ahmed, A.B.A.; Akbarsha, M.A.; Rao, M.V. Antidiabetic activity of leaf and callus extracts of Aegle marmelos in rabbit. Sci. Asia 2008, 34, 317–321. [Google Scholar] [CrossRef]
- Ghajari, M.F.; Shamsaei, M.; Basandeh, K.; Galouyak, M. Abrasiveness and whitening effect of charcoal-containing whitening toothpastes in permanent teeth. Dent. Res. J. 2021, 18, 51. [Google Scholar]
- Parvez, S.; Kang, M.; Chung, H.-S.; Bae, H. Naturally occurring tyrosinase inhibitors: Mechanism and applications in skin health, cosmetics and agriculture industries. Phytother. Res. 2007, 21, 805–816. [Google Scholar] [CrossRef]
- Hendriks, F.; Brokken, D.; Oomens, C.; Bader, D.; Baaijens, F. The relative contributions of different skin layers to the mechanical behavior of human skin in vivo using suction experiments. Med. Eng. Phys. 2006, 28, 259–266. [Google Scholar] [CrossRef]
- Costin, G.-E.; Hearing, V.J. Human skin pigmentation: Melanocytes modulate skin color in response to stress. FASEB J. 2007, 21, 976–994. [Google Scholar] [CrossRef]
- Hearing, V.J. Determination of melanin synthetic pathways. J. Investig. Dermatol. 2011, 131, E8. [Google Scholar] [CrossRef]
- Singh, S.; Malhotra, A.G.; Pandey, A.; Pandey, K.M. Computational model for pathway reconstruction to unravel the evolutionary significance of melanin synthesis. Bioinformation 2013, 9, 94. [Google Scholar] [CrossRef]
- Hachinohe, M.; Matsumoto, H.J. Involvement of reactive oxygen species generated from melanin synthesis pathway in phytotoxicty of L-DOPA. J. Chem. Ecol. 2005, 31, 237–246. [Google Scholar] [CrossRef]
- Juhasz, M.L.; Levin, M.K.; Marmur, E.S. The use of natural ingredients in innovative Korean cosmeceuticals. J. Cosmet. Dermatol. 2018, 17, 305–312. [Google Scholar] [CrossRef]
- Kim, T.; Kim, H.J.; Cho, S.K.; Kang, W.Y.; Baek, H.; Jeon, H.Y.; Kim, B.; Kim, D. Nelumbo nucifera extracts as whitening and anti-wrinkle cosmetic agent. Korean J. Chem. Eng. 2011, 28, 424–427. [Google Scholar] [CrossRef]
- Hosoi, J.; Abe, E.; Suda, T.; Kuroki, T. Regulation of melanin synthesis of B16 mouse melanoma cells by 1α, 25-dihydroxyvitamin D3 and retinoic acid. Cancer Res. 1985, 45, 1474–1478. [Google Scholar]
- Zhu, M.; Liu, T.; Guo, M. Current advances in the metabolomics study on lotus seeds. Front. Plant Sci. 2016, 7, 891. [Google Scholar] [CrossRef]
- Tadhani, M.; Patel, V.; Subhash, R. In vitro antioxidant activities of Stevia rebaudiana leaves and callus. Food Compos. Anal. 2007, 20, 323–329. [Google Scholar] [CrossRef]
- Santos, A.R.; Filho, V.C.; Niero, R.; Viana, A.M.; Moreno, F.N.; Campos, M.M.; Yunes, R.A.; Calixto, J.B. Analgesic effects of callus culture extracts from selected species of Phyllanthus in mice. J. Pharm. Pharmacol. 1994, 46, 755–759. [Google Scholar] [CrossRef]
- Li, H.; Piao, X.C.; Gao, R.; Jin, M.; Jiang, J.; Lian, M.L. Effect of several physicochemical factors on callus biomass and bioactive compound accumulation of R. sachalinensis bioreactor culture. Vitr. Cell. Dev. Biol.-Plant 2016, 52, 241–250. [Google Scholar] [CrossRef]
- Castro, A.H.F.; Braga, K.d.Q.; Sousa, F.M.d.; Coimbra, M.C.; Chagas, R.C.R. Callus induction and bioactive phenolic compounds production from Byrsonima verbascifolia (L.) DC. (Malpighiaceae). Rev. Ciência Agronômica 2016, 47, 143–151. [Google Scholar]
- Benjamin, E.D.; Ishaku, G.A.; Peingurta, F.A.; Afolabi, A.S. Callus culture for the production of therapeutic compounds. Am. J. Plant Biol. 2019, 4, 76–84. [Google Scholar] [CrossRef]
- Yen, G.-C.; Duh, P.-D.; Su, H.-J.; Yeh, C.-T.; Wu, C.-H. Scavenging effects of lotus seed extracts on reactive nitrogen species. Food Chem. 2006, 94, 596–602. [Google Scholar] [CrossRef]
- Moghaddam, A.H.; Nabavi, S.M.; Nabavi, S.F.; Bigdellou, R.; Mohammadzadeh, S.; Ebrahimzadeh, M.A. Antioxidant, antihemolytic and nephroprotective activity of aqueous extract of Diospyros lotus seeds. Acta Pol. Pharm. 2012, 69, 687–692. [Google Scholar]
- Zheng, H.; Han, L.; Shi, W.; Fang, X.; Hong, Y.; Cao, Y. Research advances in lotus leaf as Chinese dietary herbal medicine. Am. J. Chin. Med. 2022, 50, 1423–1445. [Google Scholar] [CrossRef]
- Yeom, B.S.; Jang, Y.A.; Park, J.Y.; Lee, J.T.J. Anti-Wrinkle Effect, Whitening Effect and Safety Test of Nelumbo nucifera Gaertner. Korean Soc. Med. Crops Sci. 2019, 27, 84. [Google Scholar]
- Xia, J.; Lee, J.-A. Effects of Diospyros lotus L. Extracts as Natural Whitening Agents. J. Korean Soc. Cosmet. Aesthet. 2022, 12, 425–431. [Google Scholar]
- Morikawa, T.; Kitagawa, N.; Tanabe, G.; Ninomiya, K.; Okugawa, S.; Motai, C.; Kamei, I.; Yoshikawa, M.; Lee, I.-J.; Muraoka, O. Quantitative determination of alkaloids in lotus flower (flower buds of Nelumbo nucifera) and their melanogenesis inhibitory activity. Molecules 2016, 21, 930. [Google Scholar] [CrossRef]
- Cuvelier, M.E.; Richard, H.; Berset, C.J. Antioxidative activity and phenolic composition of pilot-plant and commercial extracts of sage and rosemary. J. Am. Oil Chem. Soc. 1996, 73, 645–652. [Google Scholar] [CrossRef]
- Abdoul-Azize, S. Potential benefits of jujube (Zizyphus Lotus L.) bioactive compounds for nutrition and health. J. Nutr. Metab. 2016, 2016, 2867470. [Google Scholar] [CrossRef]
- Orhan, I.E.; Deniz, F.S. Inhibition of melanogenesis by some well-known polyphenolics: A review. Curr. Pharm. Biotechnol. 2021, 22, 1412–1423. [Google Scholar] [CrossRef]
- Monmai, C.; Kim, J.-S.; Chin, J.H.; Lee, S.; Baek, S.-H. Inhibitory Effects of Polyphenol-and Flavonoid-Enriched Rice Seed Extract on Melanogenesis in Melan-a Cells via MAPK Signaling-Mediated MITF Downregulation. Int. J. Mol. Sci. 2023, 24, 11841. [Google Scholar] [CrossRef]
- Allam, A.E.; Nafady, A.M.; Nakagawa, T.; Takemoto, N.; Shimizu, K. Effect of polyphenols from Vicia faba L. on lipase activity and melanogenesis. Nat. Prod. Res. 2018, 32, 1920–1925. [Google Scholar] [CrossRef]
- Qi, Y.; Liu, J.; Liu, Y.; Yan, D.; Wu, H.; Li, R.; Jiang, Z.; Yang, Y.; Ren, X. Polyphenol oxidase plays a critical role in melanin formation in the fruit skin of persimmon (Diospyros kaki cv.‘Heishi’). Food Chem. 2020, 330, 127253. [Google Scholar] [CrossRef]
- Leong, S. Who’s the fairest of them all? Television ads for skin-whitening cosmetics in Hong Kong. Asian Ethn. 2006, 7, 167–181. [Google Scholar] [CrossRef]
- Burger, P.; Landreau, A.; Azoulay, S.; Michel, T.; Fernandez, X.J.C. Skin whitening cosmetics: Feedback and challenges in the development of natural skin lighteners. Cosmetics 2016, 3, 36. [Google Scholar] [CrossRef]
- Nakamura, S.; Nakashima, S.; Tanabe, G.; Oda, Y.; Yokota, N.; Fujimoto, K.; Matsumoto, T.; Sakuma, R.; Ohta, T.; Ogawa, K.J.B.; et al. Alkaloid constituents from flower buds and leaves of sacred lotus (Nelumbo nucifera, Nymphaeaceae) with melanogenesis inhibitory activity in B16 melanoma cells. Bioorganic Med. Chem. 2013, 21, 779–787. [Google Scholar] [CrossRef]
- Huang, C.F.; Chen, Y.W.; Yang, C.Y.; Lin, H.Y.; Way, T.D.; Chiang, W.; Liu, S.H. Extract of lotus leaf (Nelumbo nucifera) and its active constituent catechin with insulin secretagogue activity. Food Chem. 2011, 59, 1087–1094. [Google Scholar] [CrossRef]
- Liu, W.; Yi, D.-D.; Guo, J.-L.; Xiang, Z.-X.; Deng, L.-F.; He, L. Nuciferine, extracted from Nelumbo nucifera Gaertn, inhibits tumor-promoting effect of nicotine involving Wnt/β-catenin signaling in non-small cell lung cancer. J. Ethnopharmacol. 2015, 165, 83–93. [Google Scholar] [CrossRef]
- Shu, G.; Yue, L.; Zhao, W.; Xu, C.; Yang, J.; Wang, S.; Yang, X. Isoliensinine, a bioactive alkaloid derived from embryos of Nelumbo nucifera, induces hepatocellular carcinoma cell apoptosis through suppression of NF-κB signaling. J. Agric. Food Chem. 2015, 63, 8793–8803. [Google Scholar] [CrossRef]
- Chang, C.-H.; Ou, T.-T.; Yang, M.-Y.; Huang, C.-C.; Wang, C.-J. Nelumbo nucifera Gaertn leaves extract inhibits the angiogenesis and metastasis of breast cancer cells by downregulation connective tissue growth factor (CTGF) mediated PI3K/AKT/ERK signaling. J. Ethnopharmacol. 2016, 188, 111–122. [Google Scholar] [CrossRef]
- Qi, Q.; Li, R.; Li, H.-Y.; Cao, Y.-B.; Bai, M.; Fan, X.-J.; Wang, S.-Y.; Zhang, B.; Li, S. Identification of the anti-tumor activity and mechanisms of nuciferine through a network pharmacology approach. Acta Pharmacol. Sin. 2016, 37, 963–972. [Google Scholar] [CrossRef]
- Agullo, G.; Gamet-Payrastre, L.; Manenti, S.; Viala, C.; Rémésy, C.; Chap, H.; Payrastre, B. Relationship between flavonoid structure and inhibition of phosphatidylinositol 3-kinase: A comparison with tyrosine kinase and protein kinase C inhibition. Biochem. Pharmacol. 1997, 53, 1649–1657. [Google Scholar] [CrossRef]
- Park, H.-Y.; Perez, J.M.; Laursen, R.; Hara, M.; Gilchrest, B.A. Protein kinase C-β activates tyrosinase by phosphorylating serine residues in its cytoplasmic domain. J. Biol. Chem. 1999, 274, 16470–16478. [Google Scholar] [CrossRef]
- Park, H.-Y.; Russakovsky, V.; Ohno, S.; Gilchrest, B. The beta isoform of protein kinase C stimulates human melanogenesis by activating tyrosinase in pigment cells. J. Biol. Chem. 1993, 268, 11742–11749. [Google Scholar] [CrossRef]
- Park, S.; Choi, H.; Kim, Y.J. Inhibition of Isorhamnetin on [beta]-Catenin/Tcf Signaling and [beta]-Catenin-Activated Melanogenesis. J. Basic Appl. Sci. 2013, 9, 401. [Google Scholar] [CrossRef]
- Sun, L.; Pan, S.; Yang, Y.; Sun, J.; Liang, D.; Wang, X.; Xie, X.; Hu, J. Toll-like receptor 9 regulates melanogenesis through NF-κB activation. Exp. Biol. Med. 2016, 241, 1497–1504. [Google Scholar] [CrossRef]
- Chung, B.Y.; Kim, S.Y.; Jung, J.M.; Won, C.H.; Choi, J.H.; Lee, M.W.; Chang, S.E. The antimycotic agent clotrimazole inhibits melanogenesis by accelerating ERK and PI 3K-/Akt-mediated tyrosinase degradation. Exp. Dermatol. 2015, 24, 386–388. [Google Scholar] [CrossRef]
- Singh, P.; Bhat, S.S.; Singh, N.; Venkanna, B.U.; Mohamed, R.; Rao, R.P. Cell-Based Model Systems for Validation of Various Efficacy-Based Claims for Cosmetic Ingredients. Cosmetics 2022, 9, 107. [Google Scholar] [CrossRef]
- Dobrev, H.P. Ethical aspects of cosmetic testing. In Practical Aspects of Cosmetic Testing; Springer: Cham, Switzerland, 2020; pp. 15–25. [Google Scholar]
- Günther, C.; Kowal, K.; Schmidt, T.; Jambrecina, A.; Toner, F.; Nave, R. Comparison of in vitro and in vivo percutaneous absorption across human skin using BAY1003803 formulated as ointment and cream. Clin. Pharmacol. Drug Dev. 2020, 9, 582–592. [Google Scholar] [CrossRef]
- Rosita, N.; Sultani, A.A.; Hariyadi, D.M. Penetration study of p-methoxycinnamic acid (PMCA) in nanostructured lipid carrier, solid lipid nanoparticles, and simple cream into the rat skin. Sci. Rep. 2022, 12, 19365. [Google Scholar] [CrossRef]
- Supe, S.; Takudage, P. Methods for evaluating penetration of drug into the skin: A review. Ski. Res. Technol. 2021, 27, 299–308. [Google Scholar] [CrossRef]

| Medium Components | mg/L |
|---|---|
| NH4NO3 | 825 |
| KNO3 | 950 |
| MgSO4∙7H2O | 185 |
| MnSO4∙H2O | 11.2 |
| ZnSO4∙7H2O | 4.3 |
| CuSO4∙5H2O | 0.013 |
| KH2PO4 | 85 |
| KI | 0.42 |
| CoCl2∙6H2O | 0.013 |
| CaCl2∙2H2O | 220 |
| H3BO3 | 3.1 |
| Na2MoO4∙2H2O | 0.13 |
| FeSO4∙7H2O | 13.93 |
| Na2 –EDTA | 18.63 |
| Myo-inositol | 6000 |
| Thiamine HCl | 0.4 |
| 2,4-Dichlorophenoxyacetic acid | 0.3 |
| 6-benzyladenin | 1 |
| Sucrose | 30,000 |
| Gelrite | 4000 |
| pH adjusted to 5.8 Sterilized at 121℃ for 15 min | |
| Bright & Clear | ![]() | Dark & Dull | |||||||
| 1 | 2 | 3 | 4 | 5 | 6 | 7 | 8 | 9 | 10 |
Disclaimer/Publisher’s Note: The statements, opinions and data contained in all publications are solely those of the individual author(s) and contributor(s) and not of MDPI and/or the editor(s). MDPI and/or the editor(s) disclaim responsibility for any injury to people or property resulting from any ideas, methods, instructions or products referred to in the content. |
© 2023 by the authors. Licensee MDPI, Basel, Switzerland. This article is an open access article distributed under the terms and conditions of the Creative Commons Attribution (CC BY) license (https://creativecommons.org/licenses/by/4.0/).
Share and Cite
Moon, S.H.; Kim, E.; Kim, H.-I.; Kim, S.-Y.; Seo, H.-H.; Lee, J.H.; Lee, M.-S.; Lee, S.-K.; Moh, S.H.; Bae, S. Skin-Whitening Effect of a Callus Extract of Nelumbo nucifera Isolate Haman. Plants 2023, 12, 3923. https://doi.org/10.3390/plants12233923
Moon SH, Kim E, Kim H-I, Kim S-Y, Seo H-H, Lee JH, Lee M-S, Lee S-K, Moh SH, Bae S. Skin-Whitening Effect of a Callus Extract of Nelumbo nucifera Isolate Haman. Plants. 2023; 12(23):3923. https://doi.org/10.3390/plants12233923
Chicago/Turabian StyleMoon, Sung Ho, Euihyun Kim, Hye-In Kim, Soo-Yun Kim, Hyo-Hyun Seo, Jeong Hun Lee, Min-Sup Lee, Seung-Ki Lee, Sang Hyun Moh, and Seunghee Bae. 2023. "Skin-Whitening Effect of a Callus Extract of Nelumbo nucifera Isolate Haman" Plants 12, no. 23: 3923. https://doi.org/10.3390/plants12233923
APA StyleMoon, S. H., Kim, E., Kim, H.-I., Kim, S.-Y., Seo, H.-H., Lee, J. H., Lee, M.-S., Lee, S.-K., Moh, S. H., & Bae, S. (2023). Skin-Whitening Effect of a Callus Extract of Nelumbo nucifera Isolate Haman. Plants, 12(23), 3923. https://doi.org/10.3390/plants12233923


